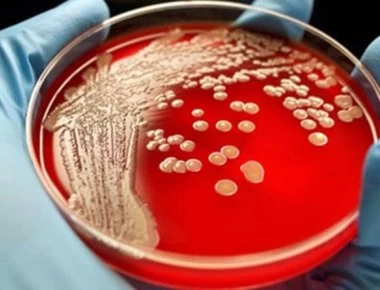
Αυτά είναι τα τρία «τέρατα» που ζουν μέσα στο ανθρώπινο σώμα

ΥΓΕΙΑ
-

Αυτά είναι τα φάρμακα που εμποδίζουν την εμφάνιση της άνοιας
Μειωμένο κίνδυνο εκδήλωσης άνοιας φαίνεται να έχουν άνθρωποι που λαμβάνουν αντιυπερτασική φαρμακευτική αγωγή. Σε αυτό το συμπέρασμα φαίνεται να καταλήγει έρευνα που δημοσιεύτηκε στο Journal of Alzheim...
Read More » -

Έτσι θα διατηρείτε το ψωμί φρέσκο για πολλές μέρες
Το φρέσκο ψωμί είναι από τις νοστιμότερες γευστικές απολαύσεις. Πολύ διαμαρτύρονται ότι το ψωμί που αγοράζουν, μπαγιατεύει γρήγορα. Μεγάλο ρόλο παίζει και ο φούρνο από τον οποίο αγοράζετε, αλλά και το...
Read More » -

Οι τέσσερις τρόποι να ρίξετε τη χοληστερίνη με διατροφή
Πολλοί άνθρωποι καταφέρνουν να θέσουν υπό έλεγχο την ανεβασμένη χοληστερίνη τους απλώς και μόνο κάνοντας μερικές αλλαγές στη διατροφή τους Για παράδειγμα, για όσους καταναλώνουν φανατικά κόκκινο κρέας...
Read More » -

Αλλεργία στο Wi-Fi: Τι συμπτώματα θα νιώσετε – Τι λέει ο Π.Ο.Υ (βίντεο)
Καθώς η εκβιομηχανοποίηση και η τεχνολογική επανάσταση είναι ακόμα εν εξελίξει στην σύγχρονη κοινωνία, υπάρχει μια πολύ μεγάλη αύξηση του αριθμού και της ποικιλίας των πηγών που εκπέμπουν ηλεκτρομαγνη...
Read More » -

Αφυδάτωση: Πώς να την αποφύγετε με αυτούς τους 6 τρόπους
Η θερμοκρασία έχει ανέβει και ο υδράργυρος θα «χτυπήσει» κόκκινο. Ιδιαίτερα τις ζεστές ημέρες πρέπει να διατηρούμε τον οργανισμό μας ενυδατωμένο για να μην έχουμε τις συνέπειες της αφυδάτωσης.Όσο η πε...
Read More » -

Φλεβίτιδα: Αίτια και συμπτώματα
Φλεβίτιδα είναι μια κατάσταση κατά την οποία μια φλέβα παθαίνει φλεγμονή, η οποία μπορεί να προκαλέσει πόνο και πρήξιμο. Όταν η φλεγμονή οφείλεται σε κάποιον θρόμβο αίματος, τότε η πάθηση ονομάζεται θ...
Read More » -

Π.Πολάκης: «Νοσηλεία κι ας είναι και σε ράντζα… » λέει για τις εικόνες ΠΟΕΔΗΝ από το «Αττικόν» (φωτο)
Υπέρ των ράντζων τάσσεται ο Παύλος Πολάκης με ανάρτησή του στο facebook. Ο αναπληρωτής Υπουργός Υγείας αναδημοσιεύει και συντάσσεται με ανακοίνωση του διοικητή του νοσοκομείου "Αττικόν" στην οποία δικ...
Read More » -
Αυτά είναι τα τρία «τέρατα» που ζουν μέσα στο ανθρώπινο σώμα
Μόνο το 10% των κυττάρων μας είναι εξ ολοκλήρου ανθρώπινα κι ας μην το γνωρίζουμε.Τα υπόλοιπα έλκουν την καταγωγή τους από ιούς, βακτήρια και παράσιτα.Μία φιλόδοξη επιστημονική προσπάθεια αποσκοπεί στ...
Read More » -

Το αρωματικό τρόφιμο που προστατεύει την καρδιά, τα αγγεία και ρίχνει τη χοληστερόλη
Η μαστίχα έχει χρησιμοποιηθεί για περισσότερα από 2.500 χρόνια ως παραδοσιακό ελληνικό φάρμακο για τη θεραπεία αρκετών ασθενειών, όπως η γαστραλγία και τα πεπτικά έλκη.Οι πρώτες αναφορές για τη μαστίχ...
Read More » -

Θυρεοειδής: Πως συνδέεται με την κολπική μαρμαρυγή – Νέα δεδομένα
Οι μεταβολές στη λειτουργία του θυρεοειδή αδένα, μπορούν να αυξήσουν τον κίνδυνο για εμφάνιση κολπικής μαρμαρυγής!Στον συσχετισμό της λειτουργίας του θυρεοειδή αδένα και της κολπικής μαρμαρυγής κατέλη...
Read More »
